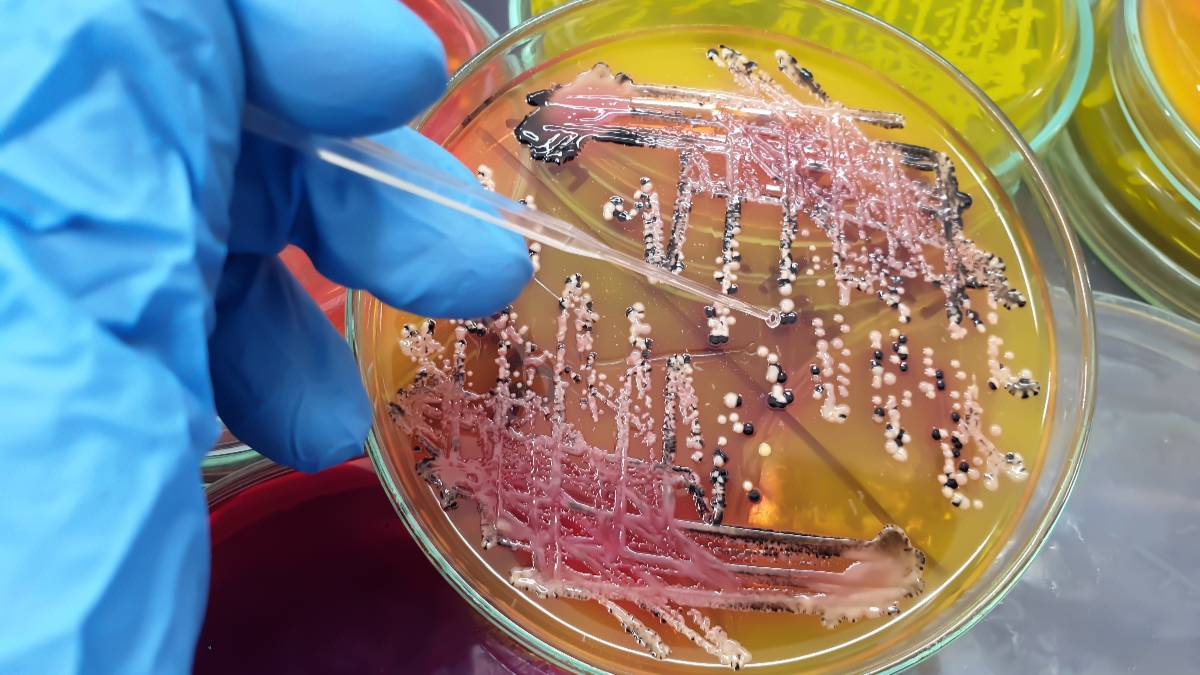

В Башкирии почти 30 воспитанников детского сада заболели кишечной инфекцией. Дошкольное учреждение временно закрыли.
В Управлении Роспотребнадзора по региону , что массовое заболевание острой кишечной инфекцией среди детей и персонала зарегистрировано в детском саду № 19 Белорецка.
"Сотрудники Роспотребнадзора детский садик закрыли и опечатали. Угрозы распространения инфекции нет", — отметили в ведомстве.
Согласно предварительным данным эпидемиологического расследования, причиной заболевания явился сальмонеллёз. По некоторой информации, всего заболело 29 детей, 19 из них госпитализированы. Остальные несовершеннолетние лечатся амбулаторно, их состояние удовлетворительное. Проверку организовала и региональная прокуратура.
Комментарии